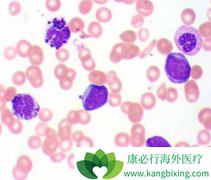

梅沙替尼 由美国礼来公司开发,用于治疗晚期实体瘤,目前将进入Ⅲ期临床试验。Ⅲ期临床试验前样品由礼来公司采用连续流技术制备,为了降低成本、缩短周期,Ⅲ期临床试验样品转移给合同加工外包公司合全药业负责,在cGMP条件下生产183 kg产品的生产周期...
分类:肿瘤资讯 作者: 日期:2023-12-26 关键词:梅沙替尼,美沙替尼,merestinib
尼洛替尼 (Nilotinib)获批治疗1岁及大于1岁的儿童慢性粒细胞白血病患者是基于CAMN107A2120和CAMN107A2203两项临床试验。这些患者可以是新诊断的Ph染色体阳性且处于慢性期者,也可以是以往经过酪氨酸激酶抑制剂治疗却发生耐药或不耐受者。这两个实验中...
分类:肿瘤资讯 作者: 日期:2018-08-10 关键词:尼洛替尼,Nilotinib